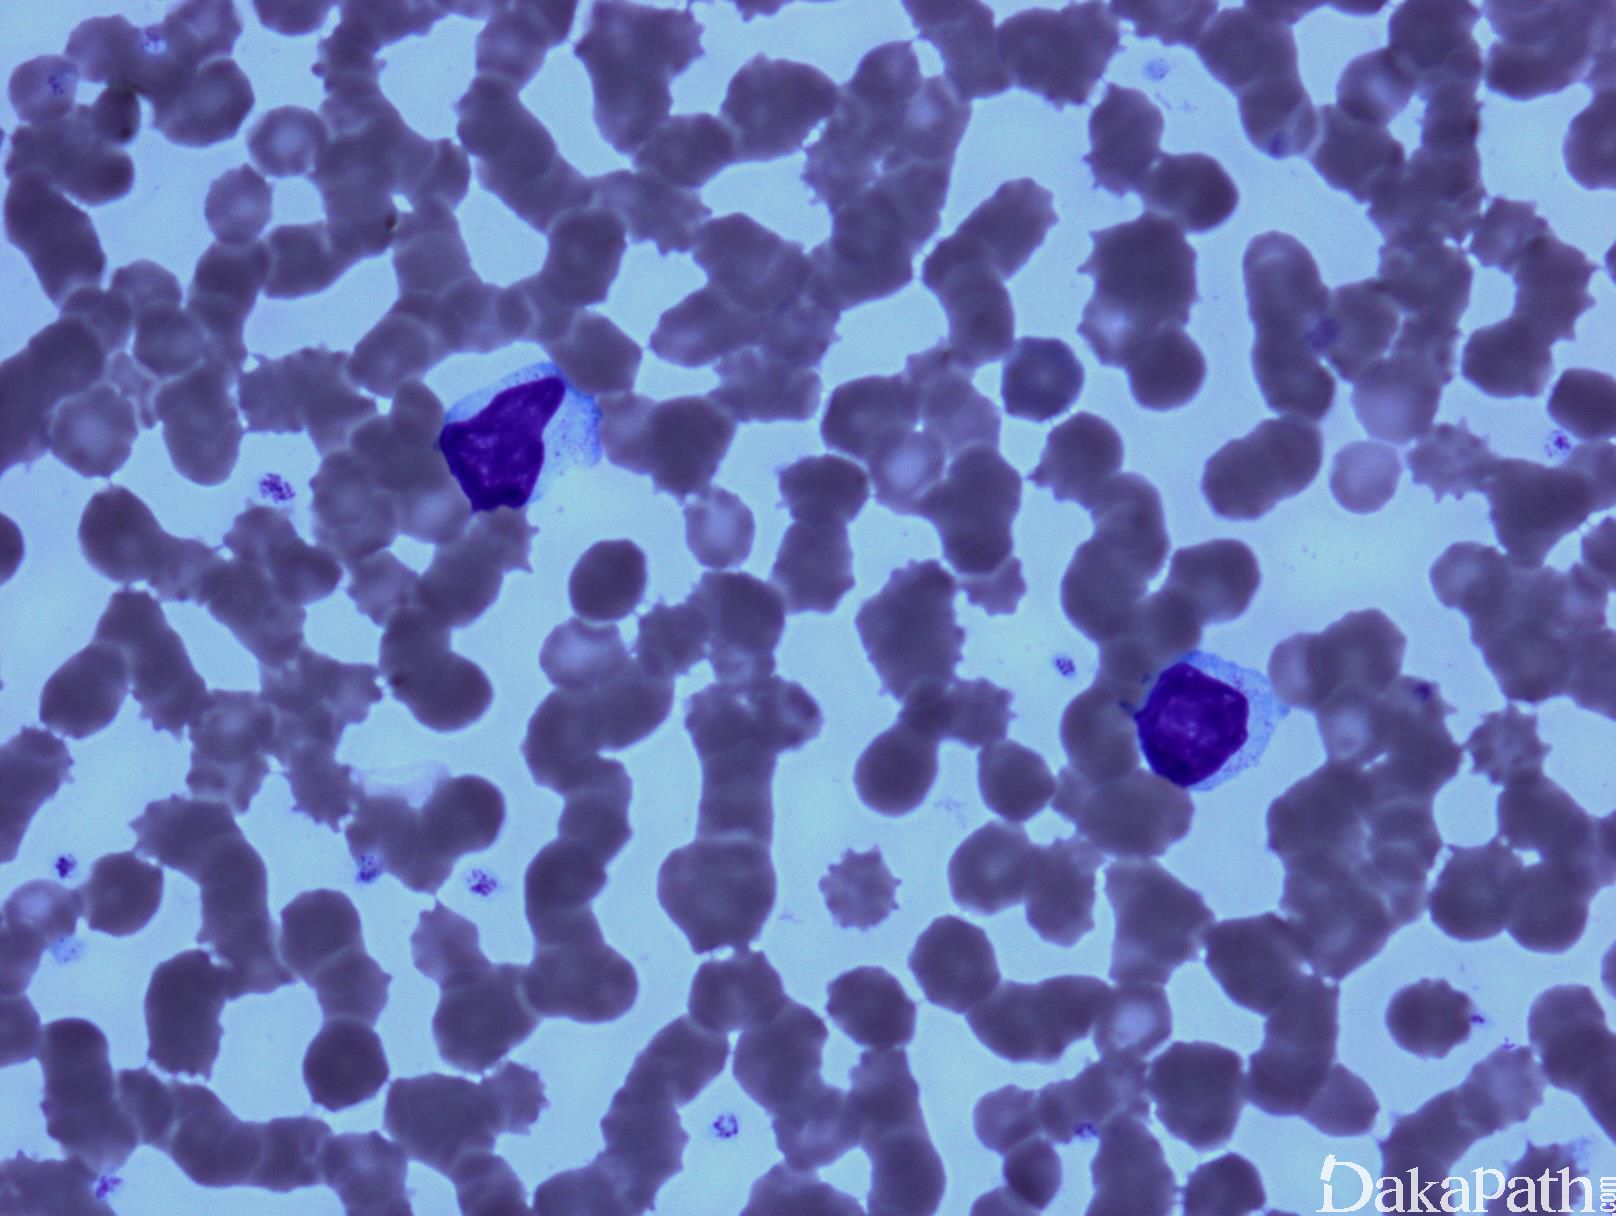

T 细胞大颗粒淋巴细胞白血病
T-Large Granular Lymphocytic Leukemia, T-LGLL
概述:
外周血中有两类大颗粒淋巴细胞(LGL):T 细胞大颗粒淋巴细胞(T-LGL)和自然杀伤细胞大颗粒淋巴细胞(NK-LGL)。 T-LGLL 系 T-LGL 的克隆性增殖,通常表现为 LGL 持续不明原因升高(一般 2-20 x 10⁹/L)超过 6 个月,表达 CD3. CD8 和 CD57,临床过程多为惰性。
诊断要点:
- 中老年发病,无症状或表现为感染(粒细胞减少)、贫血、自身免疫疾病如类风湿关节炎。白血病累及部位包括外周血、骨髓、脾和肝脏。
- 外周血大颗粒淋巴细胞持续不明原因升高,通常 ≥ 2 x 10⁹/L(有时低于此值),超过 6 个月。
- 血涂片见增生的大颗粒细胞,中等大小,核圆或轻度不规则,胞质丰富淡染,含细腻或偶尔粗大的嗜天青颗粒。形态学上不能鉴别克隆性和反应性增生。
- 骨髓浸润一般为间质,局灶或窦内,常需借助免疫组化才能发现。粒系常轻度左移,红系一般正常,但如并发纯红再障,则红系增生极度低下。
- 免疫表型:典型表型为表面 CD3+、CD2+、CD8+、CD16+、CD57+、TCRα/β(+); 少数病例可表现为 CD4+、TCR α/β+,或 TCRγ/δ+、CD8+、或 TCRCγ/δ+,CD4-、CD8-。 此外,TIA-1+、粒酶 B+、穿孔素+。常见低表达或丢失 CD5 或 CD7。 部分病例表达 KIR 家族受体。 限制性表达 TCRβ 家族谱系或异常表达 KIR 家族谱系可以作为克隆性证据。
- EBER-
- TCR 基因克隆性重组;部分病例有 STAT3 基因突变,少数有 STAT5B 突变。
变异型:
对于那些形态学类似 T-LGLL,但免疫表型为 NK 细胞的病例(即表面 CD3 阴性,不表达 TCR),分类为 NK 细胞疾病 (见鉴别诊断)。

免疫组织化学染色:
典型表型为表面 CD3+、CD8+、CD16+、CD57+、TCRα/β(+); 少数病例可表现为 CD4+、TCR α/β+,或 TCRγ/δ+、CD8+,或 TCRγ/δ+,CD4-、CD8-。 此外,TIA-1+、粒酶 B+、穿孔素+。EBER(-)
分子标记:
TCR 基因克隆性重组;部分病例有 STAT3 基因突变,少数有 STAT5B 突变
鉴别诊断:
反应性大颗粒淋巴细胞增生 :LGL 细胞短暂反应性升高,常发生于病毒感染、自身免疫性疾病、器官移植等。 LGL 形态和免疫表型正常,KIR 受体表达正常(无限制性表达), 无克隆性 TCR 基因重排。
侵袭性 NK 细胞白血病 (ANKL):病情进展迅速类似急性白血病,多器官衰竭。异形性循环大颗粒细胞(NK 细胞),EBER+
NK 细胞慢性淋巴组织增殖性疾病:临床表现和细胞形态与 T-LGLL 相似,但细胞为 NK 表型。
预后:
临床过程惰性。有研究报道中位生存期 161 月。有 STAT5B 突变着具有侵袭性,但 STAT3 突变无影响。
← T细胞幼淋巴细胞白血病 Sezary综合症 →
